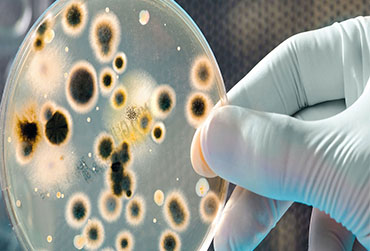
Microbiological Contamination Study and Remediation

Indoor Air Quality Assessment
As the public recognizes the importance of healthy, comfortable, and productive indoor environments,
- Read More
Chemical Exposure Monitoring
Industrial Hygiene/Chemical Exposure Monitoring is classically defined as the anticipation, recognition
- Read More
Noise Exposure Monitoring
Occupational noise-induced hearing loss is one of the most common occupational hazards.
- Read More
Compressed Air Quality Testing
Compressed air is a critical power resource in most manufacturing and process environments.
- Read More
Chemical Health Risk Assessment
An assessment of all chemicals used in the workplace in order to identify, evaluate and control any health risk ...
- Read More
Asbestos Sampling and Analysis
Asbestos is a group of six fibrous minerals that occur naturally in metamorphic deposits located around the world. ...
- Read More
Ambient Air Quality Monitoring
The Malaysia Government has established the necessary legal, institutional arrangements and guidelines to promote of environmentally...
- Read More
Cleanroom Airborne Molecular Contaminants Monitoring
Every materials introduced into cleanroom is a potential source of AMC. The chemical composition of a material, its surface ...
- Read More
Emission Monitoring as per DOE Requirement
Releasing of air impurities into the atmosphere may cause adverse health effect to human and causing economic damage....
- Read More
Gas Line Purity Sampling & Analysis
Gas purity is an analysis that the targeted purity is set at a minimum of 99.999% pure or contains no more than 0.001%....
- Read More
Microbiological Contamination Study and Remediation
Bio-decontamination is the reduction or removal of gems, mainly bacteria, Fungi and viruses. Bio-decontamination may be accomplished....
- Read More
